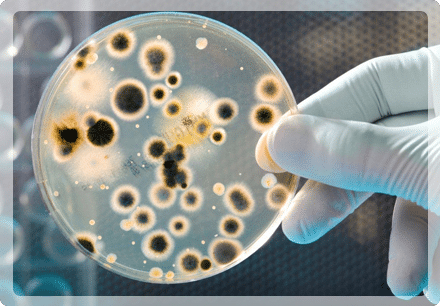
what-we-do-img-training

What We Do |
When it comes to development, each consenting Government authority has their own independent by-laws and vegetation protection orders. This information is a crucial part of residential and commercial engineering constraints. So, it’s important to get things right, especially in your report!
At Treescience, we are extensively familiar with both Queensland and New South Wales by laws and vegetation protection orders for each specific government region. This means, whether you’re wondering how to remove a tree from your backyard, develop adjacent to it and/or develop and build on land with trees, we will ensure you get the quickest, simplest, most affordable and well informed solution.

Regarding Queensland and New South Wales by laws and vegetation protection orders, a snapshot of what we mean is NALL, which in the Brisbane City Council (BCC) area stands for Natural Area Local Law. Our hassle free NALL reports for BCC will steer your project in the right direction.
If you’re unsure where you stand with your local council laws, please complete the form below and we will get back to you as soon as possible.
In addition to our report writing services, our comprehensive understanding of government policy requirements means we have the expertise to present the relevant information in a way that maximizes your chances of success. We’ll also use our experience in handling municipality and policy proceedings to ensure the environmental design and construction process is as quick and simple as possible.
We have a wealth of experience adhering to relevant Arborist and construction reporting requirements, at both local and state level government policies, as well as expertise in collaborating closely with other Statutory bodies, as project Arborists, when required.
Recent high profile assignments include Legacy Way, a $2.4 billion project in Queensland, Yarrabilba, a $4 billion community project with Lend Lease in Queensland and Airport Link, a $4.2 billion project in Queensland too. More information about our recent project works can be found here.
Using GIS (Geographic Information System) Technology, we can quickly assess the health and safety of your community urban forest, ensuring ongoing personal and public safety in around large trees.
We can also apply a range of cost-saving vegetation management strategies, which are designed to complement the surrounding environment.
I have worked with Treescience on a variety of my residential and commercial building ventures, and when it comes to Council’s development guidelines and tricky technical vegetation issues, I know that my projects are in the right hands. I enjoy working with Treescience… their team’s knowledge and professionalism is exceptional in all areas of eco management.
Residential & Commercial Property Developer & Former Brisbane Bronco
& Australian Rugby League Player
Using the latest compost and fertilizing techniques, we can help you develop a healthier food soil. We also use industry-leading tools such as Air Knife, Microscopic Analysis and Wood/Soil DNA Sequencing to remove speculation and better understand a tree’s structure and positioning under ground.
We are proud to work closely with one of Australia’s leading soil biology groups, , who are committed to assisting growers achieve true sustainable soil fertility, without the need for toxic and costly chemicals.

We provide ecological and environmental reports and advice on the relationship between the environment and organisms, including Flora and Fauna analysis, and the assessment of potential effects of proposal on threatened species, ecological communities and/or their habitats.
If you need Treescience help with your next project and are ready to get involved and give back, give us a call today on 1300 731 859 or fill in your details below.